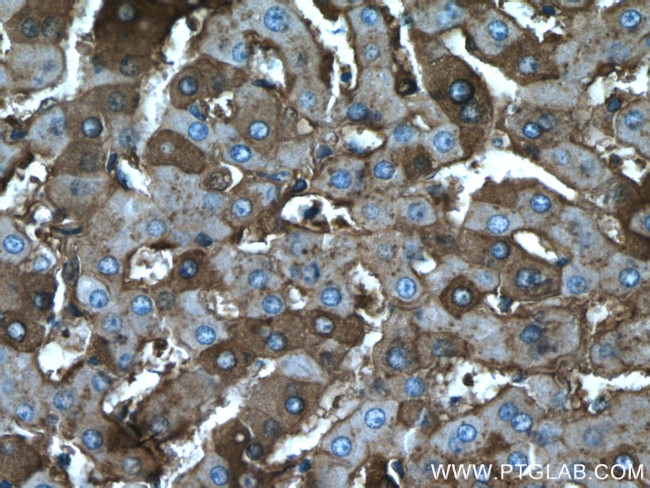
Albumin Antibody in Immunohistochemistry (Paraffin) (IHC (P))

Search
Proteintech
Albumin Polyclonal Antibody
{{$productOrderCtrl.translations['antibody.pdp.commerceCard.promotion.promotions']}}
{{$productOrderCtrl.translations['antibody.pdp.commerceCard.promotion.viewpromo']}}
{{$productOrderCtrl.translations['antibody.pdp.commerceCard.promotion.promocode']}}: {{promo.promoCode}} {{promo.promoTitle}} {{promo.promoDescription}}. {{$productOrderCtrl.translations['antibody.pdp.commerceCard.promotion.learnmore']}}
产品信息
16475-1-AP
种属反应
已发表种属
宿主/亚型
分类
类型
抗原
偶联物
形式
浓度
规格
纯化类型
保存液
内含物
保存条件
运输条件
产品详细信息
Immunogen sequence: SKLVTDLTK VHTECCHGDL LECADDRADL AKYICENQDS ISSKLKECCE KPLLEKSHCI AEVENDEMPA DLPSLAADFV ESKDVCKNYA EAKDVFLGMF LYEYARRHPD YSVVLLLRLA KTYETTLEKC CAAADPHECY AKVFDEFKPL VEEPQNLIKQ NCELFEQLGE YKFQNALLVR YTKKVPQVST PTLVEVSRNL GKVGSKCCKH PEAKRMPCAE DYLSVVLNQL CVLHEKTPVS DRVTKCCTES LVNRRPCFSA LEVDETYVPK EFNAETFTFH ADICTLSEKE RQIKKQTALV ELVKHKPKAT KEQLKAVMDD FAAFVEKCCK ADDKETCFAE EGKKLVAASQ AALGL (256-609 aa encoded by BC034023)
靶标信息
Albumin is a soluble, monomeric protein which comprises about one-half of the blood serum protein. Albumin functions primarily as a carrier protein for steroids, fatty acids, and thyroid hormones and plays a role in stabilizing extracellular fluid volume. Albumin is a globular unglycosylated serum protein of molecular weight 65,000. Albumin is synthesized in the liver as preproalbumin which has an N-terminal peptide that is removed before the nascent protein is released from the rough endoplasmic reticulum. The product, proalbumin, is in turn cleaved in the Golgi vesicles to produce the secreted albumin.
仅用于科研。不用于诊断过程。未经明确授权不得转售。
生物信息学
蛋白别名: Albumin; albumin 1; GIG20; GIG42; serum albumin; unnamed protein product
基因别名: ALB; Alb-1; Alb1; Albza; FDAHT; GIG20; GIG42; HSA; PRO0883; PRO0903; PRO1341; PRO1708; PRO2044; PRO2619; PRO2675; UNQ696/PRO1341
UniProt ID: (Human) P02768, (Rat) P02770, (Mouse) P07724
Entrez Gene ID: (Human) 213, (Rat) 24186, (Mouse) 11657